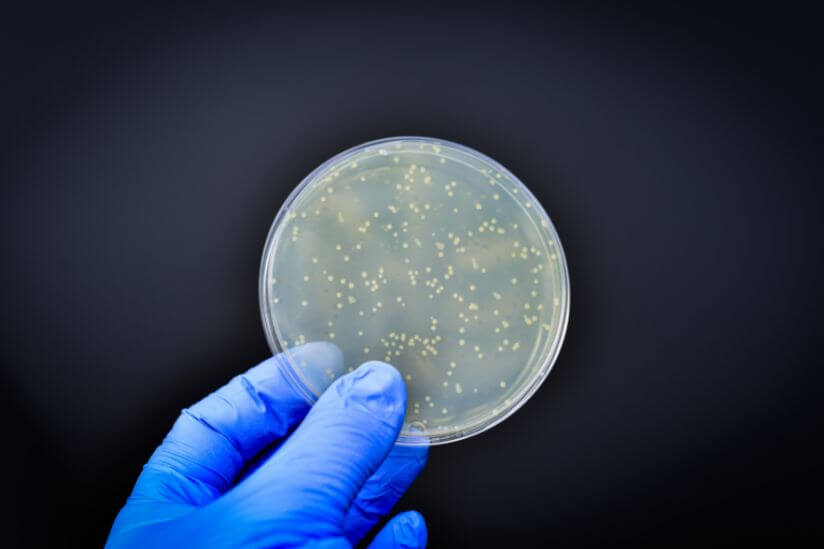
Bakterien im Pool

Ist Chlor schädlich für Haut, Haare, Pflanzen und Hunde?

Als Hobbygärtner liegt Ihnen das Wohl Ihrer Pflanzen ebenso am Herzen wie das der tierischen Gartenmitbewohner. Dank Ihrer Pflege und Schutzmaßnahmen gedeiht das Grün im Garten. Unsere Kunden fragen immer wieder nach der Schädlichkeit von Chlor im Garten. Viele sind sich dessen bewusst, dass Chlor eine Chemikalie ist, die oft zur Reinigung eingesetzt wird. Doch welche Auswirkungen Chlor haben kann, mit dem das Badewasser im Gartenpool und Hot Tub gereinigt wird, ist oft unklar. Wir geben die Antwort, ob Chlor schädlich ist für Haut, Heere, Pflanzen und Hunde!
Bevor wir Sie gleich mit der Wirkung von Chlor auf Pflanzen, Tiere und Menschen bekannt machen, stellen wir die Chemikalie zunächst einmal näher vor!
Was ist Chlor?
Chlor ist ein chemisches Element. Sein Symbol lautet: Cl. Wie Fluor, Brom und Iod gehört Chlor zu den Halogenen. Sogenanntes elementares Chlor ist unter Normalbedingungen gasförmig und gelblich-grün. Weil Chlor mit fast allen anderen Elementen und vielen Verbindungen reagiert, gilt es als eines der reaktivsten Elemente überhaupt. Die Reaktionsfreudigkeit von elementarem Chlor begründet auch seine Giftigkeit.
Was passiert, wenn Chlor auf Wasser trifft?
Eine wichtige Reaktion für die eingangs gestellte Frage, ob Chlor im Garten schädlich ist, ist die mit Wasser. Dazu müssen Sie wissen: Gibt man Chlor in Wasser, reagiert es langsam und bildet einerseits hypochlorige Säure sowie Salzsäure. Die erste wirkt stark oxidierend: Sie bleicht und desinfiziert. Die Bleichkraft von Chlor machte man sich insbesondere bei der Herstellung von weißem Papier zunutze. Da dabei jedoch auch krebserzeugende Verbindungen entstehen können, kommen inzwischen auch ungefährlichere Bleichverfahren zum Einsatz.
Die desinfizierende Wirkung des Hypochlorits, das entsteht, wenn Chlor mit Wasser reagiert, dient seit Langem der Wasseraufbereitung: Mit der sogenannten Chlorung reinigt man Trinkwasser ebenso wie Schwimmbadwasser, Poolwasser und Hot-Tub-Wasser von Bakterien. Das Umweltbundesamt (UBA) schreibt dazu, dass die Badegäste das Badewasser von Schwimmbädern verunreinigen würden, unter anderem mit Mikroorganismen wie Bakterien.
Die Mehrzahl dieser Mikroorganismen sei demnach zwar harmlos. Doch es könnten auch Erreger übertragbarer Krankheiten darunter sein. Die Verunreinigungen und Mikroorganismen würden in der Badewasseraufbereitung ständig aus dem Badewasser entfernt. Danach gebe man dem gereinigten Badewasser Chlor oder Hypochlorit zur Desinfektion zu, bevor es zurück ins Becken geleitet werde. Diese Desinfektion bewirke, dass von den Krankheitserregern, die ein Badegast möglicherweise ins Wasser abgebe, innerhalb von 30 Sekunden nur noch einer von 10.000 infektiös sei.
Welche Risiken birgt Chlor im Trink- und Badewasser?
Sie müssen wissen, dass die desinfizierenden Verbindungen im gechlorten Wasser schnell abgebaut werden. In einer Studie heißt es, dass Natriumhypochlorit, das in Haushaltsabwasser gelange, mit organischen Substanzen reagiere und beseitigt werde, noch ehe es die Umwelt erreiche. Chlor halte sich demnach auch nicht in der Atmosphäre.
Tests der EU zur Risikobewertung chlorinierter Nebenprodukte am gesamten Abstrom von chloriniertem ungeklärtem Abwasser hätten zudem ergeben, dass die vorhandenen halogenierten Nebenprodukte weder die Toxizität erhöhten noch die biologische Abbaubarkeit des Abwassers senkten. Da es sich hier um einen „realistischen Extremfall“ handele, sollte es keinen Grund für Bedenken gegenüber halogenierten Nebenprodukten geben, die mit der Verwendung von Chlor in aquatischer Umgebung erzeugt würden. Dasselbe sei für den Bereich unserer Atmosphäre gefolgert worden.
In der Studie ist weiter zu lesen, dass laut der Weltgesundheitsorganisation (WHO) „keine besonderen nachteiligen Auswirkungen durch die Behandlung“ von Trinkwasser mit Chlor bekannt seien, vorausgesetzt, der WHO-Richtwert für Chlor von 5 Milligramm pro Liter (mg/l), der demnach zurückhaltend festgesetzt worden sei, werde eingehalten. Deutschland hat vergleichsweise niedrige Grenzwerte für Chlor im Leitungswasser: Die Trinkwasserverordnung lässt maximal 0,3 mg/l an freiem Chlor zu.
Ein Zuviel an freiem Chlor im Poolwasser oder Hot-Tub-Wasser kann die Augen brennen lassen, die Haut irritieren und die Schleimhäute sowie Atemwege reizen. Zudem reagiert der Körper auch auf das aus dem Zuviel an freiem Chlor resultierende Zuviel an Chlorverbindungen, die beim Desinfizieren entstanden sind, als das Chlor mit menschlichen Mitbringseln wie Urin, Schweiß, Sonnenschutzmitteln, Kosmetika und mehr reagierte. Die dabei entstehenden Chlorverbindungen, die übrigens den typischen Chlorgeruch erst verursachen, reizen ähnlich wie freies Chlor.
Spezial: Ist Chlor schädlich für die Haare?
Noch ein Wort zu der Wirkung von Chlor auf Haare: Chlor verändert infolge einer chemischen Reaktion die physikalische Beschaffenheit der Haare. Es greift die natürliche Schuppen- und Fettschicht der Haare an. Und mitunter verfärbt es mit seiner bleichenden Wirkung Haare auch, insbesondere hell blondierte.
Wie kommt das Chlor überhaupt in den Garten?
- Wenn Sie zum Beispiel einen Pool oder einen Hot Tub im Garten stehen haben, wie Sie sie in unserem Onlineshop kaufen können, kann das zur Desinfizierung gegebenenfalls gechlorte Badewasser beim Baden auf den Rasen und umstehende Pflanzen spritzen.
- Auch wenn Sie altes Badewasser kontrolliert aus dem Pool oder Hot Tub ablassen und zum Gießen benutzen, können sich darin Chlorrückstände befinden.
- Und falls Sie Chlor zum Putzen von Gartenwerkzeugen oder Gartenmöbeln verwenden, kann die Chemikalie in den Boden und so zu in der Nähe stehenden Pflanzen gelangen.
Für die Restmenge, die an Chlor im Badewasser (Spritzwasser) beziehungsweise Gießwasser noch steckt – und damit für seine Verträglichkeit, ist entscheidend, wie Sie Ihr Poolwasser oder Hot-Tub-Wasser gechlort haben. Denn Chlortabletten, Chlorgranulat und Flüssigchlor zersetzen sich unterschiedlich.
- Granulat lässt sich beispielsweise nicht nur leichter dosieren als eine Tablette, sondern löst sich meist auch schneller auf. Auch im Gießwasser baut es sich dann entsprechend zügiger ab.
- Flüssigchlor muss sich nicht erst zersetzen, sondern baut sich sofort ab. Pi mal Daumen und in Abhängigkeit vom Chlorgehalt im Flüssig-Chlor gerechnet, können Sie damit gechlortes Wasser nach ein bis zwei Tagen zum Gießen benutzen.
Noch ein Wort zur Stoßchlorung bei starker Wasserverschmutzung: Dabei kommt Chlor in höherer Dosierung zum Einsatz. Sie sollten mindestens eine Woche warten, bis Sie das Wasser im Garten vergießen. Andernfalls drohen ernste Schäden an Pflanzen und Tieren.
Ist Chlorwasser schädlich für Blumen?
Die Empfindlichkeit gegenüber Chlor variiert von Pflanze zu Pflanze. Während die einen robust gegenüber Chlor sind, reagieren die anderen darauf höchst sensibel und Chlor kann schädlich für diese sein.
Erfahrungsgemäß vertragen Blumen im Beet Gießwasser mit Chlor eher als Blumen in Hochbeeten oder Pflanzgefäßen, weil sich das Gießwasser im Beet rascher und tiefer verteilen kann.
Grundsätzlich sollten Sie wissen, dass Chlor als wässerige Lösung überall natürlich vorkommt. Pflanzen nehmen das in der Pflanzenkunde auch als Spurenelement bezeichnete Chlor über ihre Wurzeln und/oder über ihre Blätter auf. Aber: Das natürlich vorkommende Chlor kommt meist als Chlorid vor. Zur Wasserdesinfektion nutzt man dagegen eher das ähnliche Natriumhypochlorid.
Wie wirkt zu viel Chlor im Gießwasser auf Ihren Rasen?
Zu viel Chlor im Gießwasser kann den Rasen beeinträchtigen und zu dessen Braunfärbung und sogar Absterben führen. Eine übermäßige Chlorbelastung kann auch die Nährstoffaufnahme des Rasens beeinträchtigen und ihn so weniger widerstandsfähig gegen Schädlinge und Krankheiten machen.
Ist Chlorwasser schädlich für Ihren Hund?
Ein Bad in einem vorschriftsgemäß gechlorten Pool schadet Ihrem Hund ebenso wenig wie Ihnen. Aber: Die Augen und Ohren von Hunden reagieren oft empfindlicher auf gechlortes Poolwasser als die von ihrem Zweibeiner. Sie sind daher auch anfälliger.
- Lassen Sie Ihren Hund erst in den gechlorten Pool, wenn auch Sie dort ohne Bedenken reinspringen würden.
- Beaufsichtigen Sie Ihren Hund beim Bad lückenlos.
- Verstauen Sie Chlorvorräte sicher: kinder- und hundesicher.
- Spülen Sie das Hundefell nach jedem Bad in gechlortem Wasser mit klarem Wasser, um Chlorreste zu entfernen.
- Bieten Sie Ihrem Hund nahe dem Pool Trinkwasser an, damit er gar nicht erst auf die Idee kommt, dass der Pool ein riesiger Wassernapf sei.
So schützen Sie Ihren Garten vor einer Chlorbelastung
Sie haben verschiedene Möglichkeiten, um Ihren Garten vor Chlor zu schützen. Wenn Sie einen Pool oder einen Hot Tub besitzen, sollten Sie sicherstellen, dass die Chemikalie nicht direkt auf den Rasen oder die umliegenden Pflanzen gerät. Verwenden Sie stattdessen eine passende Abdeckung oder legen Sie einen ausreichend großen Bereich mit einer speziellen Auskleidung an, um das Chlor aufzufangen.
Mehr zur Pflege und Reinigung von Gartenmöbeln lesen Sie in unserem Bitrag: Gartenmöbel reinigen: Putzanleitung für Möbel aus Holz, Metall und Kunststoff.
Statt Chlor im Garten: Alternative Methoden zur Reinigung von Pools und Hot Tubs
Es gibt viele alternative Methoden zur Reinigung von Pools und zum Badefass Wasser reinigen, die keine Verwendung von Chlor erfordern.
- Zum Beispiel können Sie Salzwasser verwenden, um Ihren Pool oder Hot Tub zu reinigen. Salzwasser ist sanfter für die Haut und die Umwelt und kann dazu beitragen, die Anzahl der Chemikalien, die in Ihren Garten gelangen, zu reduzieren.
- Ein weiterer umweltfreundlicher Ansatz besteht darin, biologische Poolreinigungsmittel zu verwenden. Diese Reinigungsmittel verwenden natürliche Mikroorganismen, zum Beispiel Milchsäurebakterien, um organische Materialien abzubauen, die den Pool oder Hot Tub verschmutzen können. Biologische Reinigungsmittel sind sicher für Pflanzen und Tiere und können dazu beitragen, die Gesundheit Ihres Gartens zu erhalten.
Wenn Sie sich für weitere umweltfreundliche Alternativen rund um die Pflege des Gartens interessieren, schauen Sie doch mal bei unseren Beiträgen Kaffeesatz als Dünger: Eine umweltfreundliche Alternative für den Garten? und Regenwasser sammeln und nutzen: Tipps & Tricks vorbei.
Fazit: Ist Chlor schädlich?
Im Übermaß schadet Chlor Ihrem Garten. Es kann zu Braunfärbung und Absterben von Rasen, Vergilbung und Verkrüppelung von Blättern und Blüten führen und das Wachstum und die Gesundheit Ihrer Pflanzen beeinträchtigen.
Weitere Themen:
- Badefass Wasserpflege ohne Filter: So wirds was mit sauberem Wasser!
- Algen im Pool: So werden Sie sie wieder los!
***
Titelbild: ©iStock/pixinoo
Artikelbilder: Bild 1: ©iStock/Manjurul; Bild 2: ©iStock/boggy22; Bild 3: ©Gartenhaus.com/Kundenprojekt; Bild 4: ©Gartenhaus.com

Hinterlasse einen Kommentar